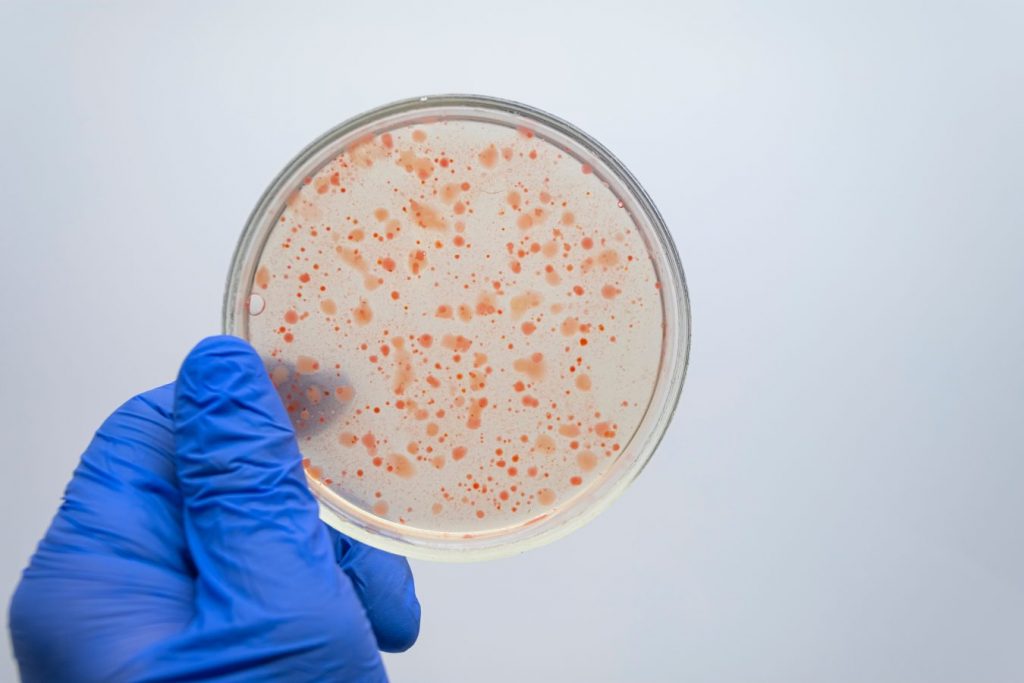

Acasă » Nutriție și farmacie » Prebioticele, surse și modalități de acțiune
Prebioticele, surse și modalități de acțiune

Prebioticele sunt substanțe de viitor care pot constitui un instrument natural, practic, ce poate contribui atât la ameliorarea sănătății digestive, cât și la obținerea unor efecte sanogenetice pe termen lung. Printre cele mai căutate suplimente alimentare ale momentului sunt cele care conțin fibre prebiotice. Acestea au efecte pozitive asupra consumatorilor, mediate întotdeauna de efecte asupra microflorei digestive a gazdei. Deși studiile clinice sunt puține în domeniu, totuși se cunosc, în mare parte, mecanismele prin care apar aceste efecte.
Prebioticele – introducere
Noțiunea de produs „prebiotic” este auzită foarte des pe piața suplimentelor alimentare în ultimii ani. De multe ori, însă, există confuzii majore în ceea ce privește definirea unui produs prebiotic. Acesta este confundat cu probioticele sau îi sunt atribuite efecte pe care nu le are. Într-adevăr, publicul nu trebuie învinuit pentru astfel de percepții neadecvate, întrucât acțiunile anumitor categorii de fibre asupra sănătății au fost studiate destul de puțin în studii clinice, ceea ce nu a permis o definire clară a acestora și a dus la postularea unor efecte mult prea optimiste, care nu se regăsesc în mențiunile de sănătate aprobate în Uniunea Europeană. În continuare, vom urmări definițiile prebioticelor și efectele studiate până în prezent.
Definiții
Prima definiție clară este relativ recentă, ea fiind emisă în 1995. De atunci, definițiile au evoluat. Le prezentăm în ordinea emiterii (după 1).
|
An |
Definiție |
Referință |
|
1995 |
Un produs alimentar nedigerabil care influențează pozitiv gazda, stimulând selectiv creșterea și/sau activitatea unuia sau unui număr limitat de tipuri de bacterii în colon, ameliorând sănătatea. |
Gibson and Roberfroid [2] |
|
2003 |
Substanțe nedigerabile care au efecte fiziologice pozitive asupra gazdei prin stimularea creșterii sau activității unui număr limitat de bacterii indigene. |
Reid et al. [3] Întâlnirea inaugurală a ISAPP |
|
2004 |
Un ingredient fermentat selectiv, ce determină schimbări specifice atât în compoziția, cât și în activitatea microflorei digestive, care determină efecte pozitive asupra sănătății și stării de bine a gazdei. |
Gibson et al. [4] |
|
2007 |
Un ingredient fermentat selectiv, ce determină schimbări specifice atât în compoziția, cât și în activitatea microflorei digestive, care determină efecte pozitive asupra sănătății și stării de bine a gazdei. |
Roberfroid [5] IDF/FAO Meeting |
|
2008 |
Un component alimentar care nu are în compoziție organisme vii și care determină beneficii pentru sănătate, asociate cu modularea microbiotei. |
Intalnirea tehnica a FAO [6] (2007) |
|
2010 |
Un ingredient fermentat selectiv care conduce la schimbări specifice ale compoziției și/sau activității microbiotei gastrointestinale, ceea ce duce la avantaje pentru sănătatea gazdei. |
Gibson et al. [7] ISAPP 6th Annual Meeting |
|
2015 |
Un compus nedigerabil care, prin metabolizarea sa de către microorganismele din tubul digestiv, modulează compoziția și/sau activitatea microbiotei digestive, ceea ce conferă beneficii fiziologice gazdei. În Europa, EFSA folosește definiția FAO, amintită anterior. |
Bindels et al. [8] |
Este clar din toate aceste definiții, că toate efectele prebioticelor se realizează prin intermediul microbilor comensali digestivi, a ceea ce numim în prezent microbiota intestinală. Microbiota a fost și ea mult studiată și s-a arătat că modificările de compoziție pe termen scurt pot fi determinate de diferiți factori, inclusiv de variația macronutrienților din dietă. Nu există doi indivizi cu microbiotă identică, dar există asemănări marcate în familii sau zone geografice.
Mai mult, variațiile temporare au tendința de a se anula în timp, microbiota revenind, de regulă, la parametrii inițiali. Printre factorii externi ce pot modifica microbiota, din punct de vedere al compoziției sau al activității, antibioticele sunt cele mai cunoscute, dar pot interveni și clima, stresul, infecțiile, neoplaziile și mulți alți factori [9].
Prebioticele și efectele asupra compoziției microbiotei
Polimorfă în general, microbiota conține și două genuri de bacterii care sunt asociate în mod special cu efecte sanogenetice. Este vorba despre lactobacili și bifidobacterii.
Lactobacilii scad inflamația intestinală [10] și joacă un rol important în ameliorarea simptomelor intoleranței la lactoză. De asemenea, ei au efect pozitiv în constipație, în sindromul intestinului iritabil și în principiu par să ajute în cazul diareei turiștilor.
Bifidobacteriile sunt primele bacterii care colonizează tubul digestiv după naștere. Sunt rezidenți normali la indivizii sănătoși și fermentează în mod special oligozaharidele. În acest fel, ele devin un marker al capacității prebiotice. Concentrația de bifidobacterii în intestin a fost asociată negativ cu obezitatea și sporul ponderal [11].
Dieta bazată pe plante, terapie adjuvantă în diabetul zaharat de tip 2?
Desigur, nu toate speciile de bifidobacterii au astfel de efecte. Studiile arată că o diminuare a populației de bifidobacterii și o scădere a diversității bacteriene intestinale se asociază cu o potențare a inflamației locale și a simptomelor intestinului iritabil [12]. Explicația acestor efecte nu a fost încă găsită, însă există un numeros corp de studii care asociază prezența lactobacililor și a bifidobacteriilor cu sănătatea.
Producerea metaboliților
Prin fermentarea directă a unor compuși selecționați, rezultă metaboliți primari și secundari corelați cu sănătatea. Principalele substanțe sanogenetice sunt acizii grași cu lanț scurt (SCFA), care sunt produși de microbiotă prin fermentarea carbohidraților și a altor substanțe care nu s-au absorbit în intestinul proximal. Cea mai mare parte (90 – 95%) din SCFA este formată din acetat, propionat și butirat. Acetatul formează jumătate din SCFA din fecalele umane și este o sursă preferată de energie pentru mușchi [13]. Propionatul și butiratul sunt corelați negativ cu unele afecțiuni determinate de exacerbarea inflamației, cum este, de exemplu, colita ulceroasă [14].
SCFA determină răspunsuri pozitive, însă amploarea lor poate fi foarte diferită de la un individ, la altul, deși se consumă același nivel de fibre. Fermentația fructanilor de tip inulină crește excreția urinară de hipurat. Acesta este metabolitul unor microorganisme și se găsește într-o cantitate mai mică la indivizii obezi, în comparație cu cei cu greutate scăzută. De asemenea, este diminuat la diabetici, față de nediabetici [15]. De aceea, excreția crescută de hipurat este considerată un efect pozitiv al consumului de inulină, o dovadă a fermentării acesteia.
Prebioticele și efectele asupra absorbției elementelor minerale
Într-o lume în care numărul fracturilor și al pacienților cu osteoporoză a crescut într-un ritm alarmant, interesul pentru acest aspect se leagă în mod special de metabolismul calciului. Creșterea biodisponibilității calciului este un deziderat major care pare a fi sprijinit de aportul prebioticelor [16]. Intestinul distal este un punct esențial de absorbție a calciului, proces care este stimulat de modificările fermentației acide, din cauza acțiunii microbiotei asupra fibrelor alimentare. Există studii clinice care au dat însă rezultate diverse.
Patru studii care au urmărit inulina, oligofructoza și galacto-oligozaharidele nu au arătat un impact asupra absorbției calciului, la un consum de 1 – 17 g pe zi. În alte șase studii în care s-au administrat aceleași prebiotice, dar și lactuloză, cu doze de 8 – 40 g pe zi, s-a dovedit un impact semnificativ. Desigur că în ecuația absorbției calciului intră mulți alți factori, îndeosebi vârsta, deoarece se știe că adolescenții și femeile la menopauză au o afinitate mai mare pentru calciu. Totuși, este un aspect care trebuie în continuare completat prin studii, deoarece prebioticele par să ofere avantaje semnificative în absorbția calciului, îndeosebi la grupele de vârstă care au cea mai mare nevoie de el.
Efectele asupra degradării proteinelor
În absența carbohidraților fermentescibili, proteinele endogene sau alimentare pot fi degradate, rezultând numeroși metaboliți dăunători: amine, amoniac, fenoli etc. Fără carbohidrați fermentescibili, concentrația de SCFA scade, iar pH-ul local crește, ceea ce duce la favorizarea degradării proteice și apariția de acizi grași ramificați, fenoli, indoli. La pacienții care iau lactuloză, markerii majori de degradare a proteinelor au scăzut substanțial. Fenolii fecali, indolii fecali, p-crezolul, skatolul și amoniacul urinar au scăzut la pacienții cărora li s-a administrat lactuloză. Tratamentul cu inulină pe durata a 4 săptămâni (5 g, de 3 ori pe zi) a determinat reducerea amoniacului fecal și urinar [17]. Studii similare, efectuate cu amidon rezistent, au arătat că acesta scade amoniacul fecal, dar nu și pe cel urinar. Arabinooligozaharidele au scăzut p-crezolul urinar [18].
Modificarea populațiilor microbiene patogene
Mucoasa intestinală și microbiota locală sunt cele două elemente-cheie în lupta cu invazia bacteriilor patogene. Mai multe tipuri de patogeni sunt inhibați: E. coli, Salmonella spp, Campylobacter etc. Principalele căi prin care se realizează acest lucru sunt: formarea metaboliților acizi care scad pH-ul intestinal sub cel optim pentru bacteriile patogene, competiția intermicrobiană pentru ariile de colonizare, antagonismul prin peptidele inhibitorii produse de lactobacili, competiția pentru sursele de nutrienți și stimularea sistemului imunitar [19].
Prebioticele și efectele asupra riscului de alergie
Alergiile au o etiologie complexă, dar apariția lor poate fi influențată de o colonizare necorespunzătoare a intestinului cu bacterii sau prin reducerea diversității microbiene locale. Scăderea numărului de bifidobacterii și lactobacilli s-a asociat cu apariția alergiilor în primii ani de viață [20]. Oligozaharidele din dietă au efecte imunomodulatoare, suplimentarea arătând protecție împotriva alergiilor, mai ales față de eczeme și rinoconjunctivite. Un raport Cochrane a găsit o reducere semnificativă a eczemelor la un număr mare de copii care au luat suplimente de oligozaharide [21]. Explicarea căilor prin care apar astfel de efecte este în prezent studiată atât la om, cât și la animale de laborator.
Prebioticele și efectele asupra barierei intestinale
Tubul digestiv este una din cele mai importante interfețe ale organismului uman, cu elemente sosite din mediul exterior. Celulele epiteliale formează o barieră puternic protectoare. Celule specializate formează mucine, care alcătuiesc un gel ce previne contactul direct al particulelor mari (mai ales bacterii) cu celulele epiteliale. Uneori, joncțiunile strânse dintre celule se pot relaxa și spațiul paracelular dintre celulele epiteliale poate fi compromis. Când se întâmplă acest lucru, apare de regulă inflamația. Anumite substanțe, cum ar fi claudinele, zonula occludens-1 și ocludinele sunt proteinele responsabile pentru păstrarea joncțiunilor intercelulare strânse.
Ele pot fi modulate și supresate, experimental, printr-o dietă bogată în grăsimi [22]. SCFA produși prin fermentația prebioticelor pot contribui la funcția de barieră. Studiile au arătat că aplicarea mixturilor de SCFA a mărit rezistența electrică transepitelială și a scăzut transportul paracelular al unor markeri la nivel cecal, la animale de experiență [23]. Oligofructoza promovează schimbări selective bacteriene, cu creșterea numărului de bifidobacterii, ceea ce duce la producția de GLP-2, mărind funcțiile de barieră intestinală și asigurând joncțiuni mai strânse și diminuarea inflamației [24].
Păstrarea integrității barierei gastrointestinale reduce nivelul de LPS în plasmă. LPS sunt endotoxine produse de bacterii, cu rol proinflamator determinant în apariția unor procese patologice și sunt prezente mai ales la bacteriile gram negative. LPS activează receptorului TLR4, ceea ce duce la inflamație din cauza eliberării de citokine și chemotoxine [25]. Inulina îmbogățită în oligofructoză a dovedit că poate scădea LPS plasmatice, la femeile cu diabet de tip 2.
Efectele asupra apărării imune
Se știe că numeroase celule adiacente tractului gastrointestinal au rol în imunitate. Celulele TREG, celulele T efectoare, celulele Natural Killer și celulele B sunt influențate de prebiotice și de metaboliții formați prin fermentația acestora [26]. Până în prezent, nu se cunoaște mecanismul exact de influențare a aparatului imun, dar se bănuiește că la origine ar fi formarea diverșilor metaboliți, inclusiv a SCFA. În mod particular, butiratul a dovedit că poate influența macrofagele, celulele T și celulele dendritice [26].
Din studiul literaturii de specialitate, rezultă că există numeroase cercetări care au în obiectiv prebioticele. Ele colaborează strâns cu microbiota, pe care o hrănesc și o modulează în mod activ. Deși mai sunt multe elemente de elucidat în explicarea acțiunii prebioticelor și a sistemelor pe care le influențează, ele se dovedesc a fi produse utile atât pentru menținerea sănătății digestive, cât și a celei generale și a bunăstării organismului.
Pentru ABONAMENTE și CREDITE DE SPECIALITATE click AICI!
Referințe bibliografice:
- Carlson J. L., Erickson J. M., Lloyd B. B., Slavin J. L. Health Effects and Sources of Prebiotic Dietary Fiber. Curr. Dev. Nutr. 2018;2(3):nzy005;
- Gibson G. R., Roberfroid M. B. Dietary modulation of the human colonic microbiota: introducing the concept of prebiotics. J. Nutr. 1995;125(6):1401–12;
- Reid G., Sanders M., Gaskins H. New scientific paradigms for probiotics and prebiotics. J. Clin. 2003;37(2):105–18;
- Gibson G. R., Probert H. M., Van Loo J., Rastall R. A., Roberfroid M. B. Dietary modulation of the human colonic microbiota: updating the concept of prebiotics. Nutr. Res. Rev. 2004;17(2):259–75;
- Roberfroid M. Prebiotics: The Concept Revisited. J. Nutr. 2007;137(3):830S–837S;
- Pineiro M., Asp N-G, Reid G., Macfarlane S., Morelli L., Brunser O., Tuohy K. FAO technical meeting on prebiotics. J. Clin. Gastroenterol2008;42:S156–9;
- Gibson G. R., Scott K. P., Rastall R. A., Tuohy K. M., Hotchkiss A., Dubert-Ferrandon A., Gareau M., Murphy E. F., Saulnier D., Loh G., et al. Dietary prebiotics: current status and new definition. Food Sci. Technol. Bull Funct. Foods2010;7(1):1–1;
- Bindels L. B., Delzenne N. M., Cani P. D., Walter J. Towards a more comprehensive concept for prebiotics. Nat. Rev. Gastroenterol Hepatol. 2015;12(5):303–10;
- Moloney R. D., Desbonnet L., Clarke G., Dinan T. G., Cryan J. F. The microbiome: stress, health and disease. Mamm Genome2014;25(1–2):49–74;
- Borruel N. Increased mucosal tumour necrosis factor alpha production in Crohn’s disease can be downregulated ex vivo by probiotic bacteria. Gut2002;51(5):659–64;
- Schwiertz A., Taras D., Schäfer K., Beijer S. Microbiota and SCFA in lean and overweight healthy subjects. Obesity2010;18(1):190–5;
- Joossens M., Huys G., Cnockaert M., De Preter V., Verbeke K., Rutgeerts P., Vandamme P., Vermeire S. Dysbiosis of the faecal microbiota in patients with Crohn’s disease and their unaffected relatives. Gut2011;60(5):631–7;
- Wong J. M. W., de Souza R., Kendall C. W. C., Emam A., Jenkins D. J. A. Ovid.: colonic health: fermentation and short chain fatty acids. Clin. Gastroenterol. 2006;40(3):235–43;
- Machiels K., Joossens M., Sabino J., De Preter V., Arijs I. A decrease of the butyrate-producing species Roseburia hominis and Faecalibacterium prausnitzii defines dysbiosis in patients with ulcerative colitis. Gut2014;63(8):1275–83;
- Calvani R., Miccheli A., Capuani G., Tomassini Miccheli A., Puccetti C., Delfini M., Iaconelli A., Nanni G., Mingrone G. Gut microbiome-derived metabolites characterize a peculiar obese urinary metabotype. Int. J. Obes. 2010;34(6):1095–8;
- Whisner C. M., Martin B. R., Schoterman M. H. C., Nakatsu C. H., McCabe L. D., McCabe G. P., Wastney M. E., van den Heuvel E. G., Weaver C. M. Galacto-oligosaccharides increase calcium absorption and gut bifidobacteria in young girls: a double-blind cross-over trial. Br. J. Nutr. 2013;110(7):1292–303;
- Geboes K. P., De Hertogh G., De Preter V., Luypaerts A., Bammens B., Evenepoel P., Ghoos Y., Geboes K., Rutgeerts P., Verbeke K. The influence of inulin on the absorption of nitrogen and the production of metabolites of protein fermentation in the colon. Br. J. Nutr. 2006;96(6):1078–86;
- Cloetens L., Broekaert W. F., Delaedt Y., Ollevier F., Courtin C. M., Delcour J. A., Rutgeerts P., Verbeke K. Tolerance of arabinoxylan-oligosaccharides and their prebiotic activity in healthy subjects: a randomised, placebo-controlled cross-over study. Br. J. Nutr. 2010;103(5):703–13;
- Gibson G. R., McCartney A. L., Rastall R. A. Prebiotics and resistance to gastrointestinal infections. Br. J. Nutr. 2005;93(Suppl. 1):S31–4;
- Sjögren Y., Jenmalm M. Altered early infant gut microbiota in children developing allergy up to 5 years of age. Clin. Exp. Allergy2009;39(4):518–26;
- Osborn D., Sinn J. Prebiotics in infants for prevention of allergy. Cochrane Database Syst. Rev. 2013;2013(3):CD006474;
- Suzuki T., Hara H. Dietary fat and bile juice, but not obesity, are responsible for the increase in small intestinal permeability induced through the suppression of tight junction protein expression in LETO and OLETF rats. Nutr. Metab. (Lond.)2010;7(1):19;
- Suzuki T., Yoshida S., Hara H. Physiological concentrations of short-chain fatty acids immediately suppress colonic epithelial permeability. Br. J. Nutr. 2008;100(2):297–305;
- Cani P. D., Possemiers S., Van de Wiele T., Guiot Y., Everard A., Rottier O., Geurts L., Naslain D., Neyrinck A., Lambert D. M., et al. Changes in gut microbiota control inflammation in obese mice through a mechanism involving GLP-2-driven improvement of gut permeability. Gut. 2009;58(8):1091–103;
- Nakamura Y., Omaye S. Metabolic diseases and pro- and prebiotics: mechanistic insights. Nutr. Metab. (Lond.)2012;9(1):1–11;
- Frei R., Akdis M., O’Mahony L. Prebiotics, probiotics, synbiotics, and the immune system. Curr. Opin. Gastroenterol. 2015;31(2):153–8.
Cuvinte-cheie: bifidobacterii, efect prebiotic, lactobacili, microbiota, prebiotic, prebiotice, supliment alimentar, tub digestiv
Fii conectat la noutățile și descoperirile din domeniul medico-farmaceutic!
Utilizam datele tale in scopul corespondentei si pentru comunicari comerciale. Pentru a citi mai multe informatii apasa aici.